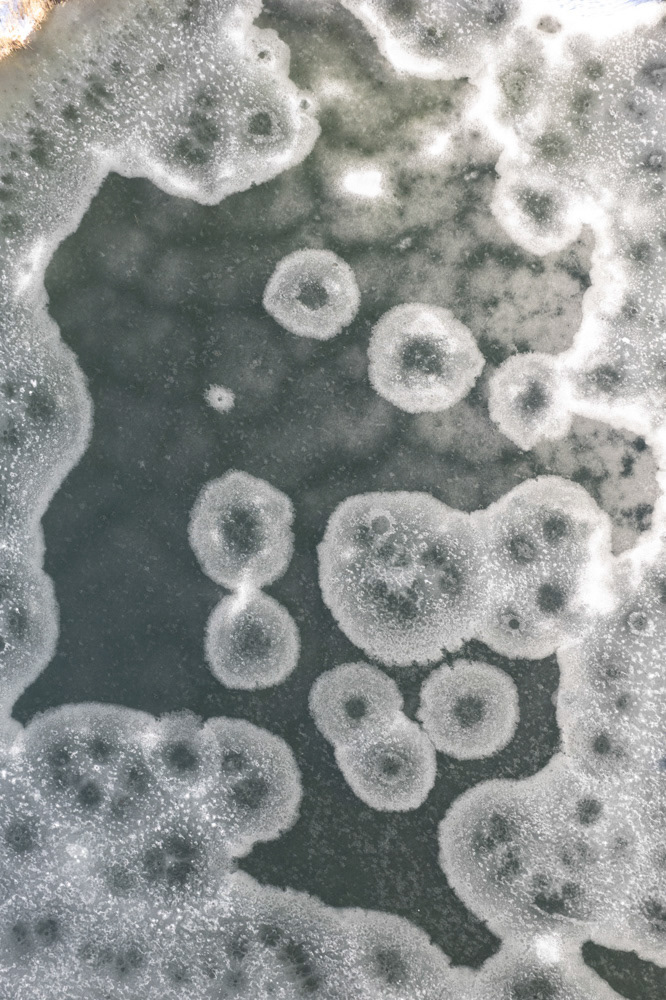

The project carried out in Lavarone, a small mountain community in the Italian Alps, aimed to develop an audio-visual survey, dedicated to the theme of cultural tourism, through a multimedia approach. During the month of December 2024, a series of meetings were held with the main local actors - mayor, president of the Green Land cooperative, librarian, Forte Belvedere director, president of the Anima Association, and forest janitor - in which through audio, video, and photographic recordings a survey was carried out on the topic of tourism from the point of view of memory and their expectations for the future. The purpose of the survey was to represent the different socio-cultural, environmental and economic needs that deal with cultural tourism in the Lavarone area. What emerges is a prototype audio-visual survey that, although experimental and, for time reasons, not as in-depth as I would have wished, turns out to be a hopefully positive indicator of the Lavarone model.
The output presented on February 3 is an installation that combines images printed on plastic material and a video projection reporting on interviews collected during the survey campaign. The purpose of the latter is to report the words of local actors, their hopes for the future and critical aspects highlighted in the Lavarone model. The purpose, on the other hand, of the printed pictures is to stimulate reflection and invite the public to leave a comment on the picture itself. In fact, the plastic material on which they are printed makes it possible to turn them into a kind of visual-textual clipboard, where anyone can leave their own mark. The strength of such a tool lies precisely in opening up interaction not only through textual language, but also allows the use of drawing and other visual signs. In this way, images become a surface that is transversal and open to exchange between adults, children, people from more structured or less structured cultural backgrounds, and not least local institutions.